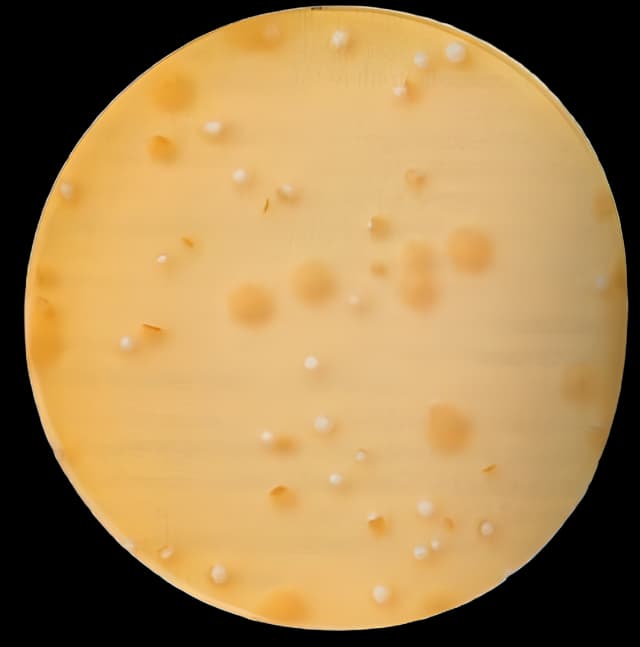
Dehydrated Culture Media BD Difco™ Lactobacilli MRS Broth Tan Dehydrated

Dehydrated Culture Media BD Difco™ Lactobacilli MRS Broth Tan Dehydrated
USAMP#53260731SKU: DF0881175BD Difco™

Product Spotlight
- Manufacturer: BD 288130
- Difco™ Lactobacilli MRS Broth powder contains peptone and dextrose
- These ingredients supply nitrogen, carbon and other elements necessary for growth